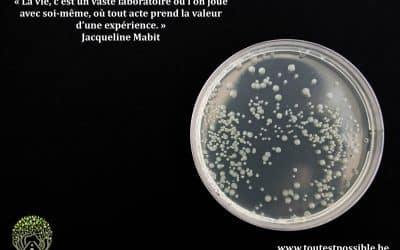
Chronique intérieure (presque) incorrecte chapitre 1

Chronique intérieure (presque) incorrecte chapitre 3
J’ai encore cru que je pouvais tout faire. C’est une croyance tenace. Presque touchante. Chaque matin, je me réveille avec cette impression très sérieuse que la journée va coopérer. Que le temps va s’étirer. Que mon énergie sera stable. Que rien d’imprévu ne viendra...
Chronique intérieure (presque) incorrecte chapitre 2
J’ai dit oui alors que je pensais non (encore). C’est souvent très rapide. Presque élégant. Quelqu’un demande quelque chose. Mon cerveau pense : non. Ma bouche répond : “oui, bien sûr”. Sans concertation préalable. Sans vote. Sans référendum intérieur. Et parfois, je...
Chronique intérieure (presque) incorrecte chapitre 1
Je vais bien. Sauf quand je pense. Il y a des jours où tout va bien. Vraiment. Personne n’est malade. Rien n’a explosé. Le monde tient à peu près debout. Et pourtant… dans ma tête, c’est réunion non-stop, sans ordre du jour, sans pause-café, et avec un mental très...